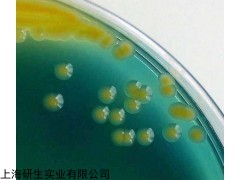

烬灰链霉菌培养【标准操作流程】
菌株复苏:(按三区划线法将留菌管内的原始菌株进行复苏)
1) 所有菌株,显色培养基分4区,每区一株,标明菌株号、菌种名常用缩写如下:
cal: 白念珠菌 cgl:光滑念珠菌 cpa: 近平滑念珠菌 ctr: 热带念珠菌 ckr: 克柔念珠菌 cne: 隐球菌,其他菌种标记全名
2) 隐球菌除传显色培养基以外,另传1/2块血平皿上述菌株统一37oC孵育48h
菌种鉴定:(48h后观察结果)
中文名称
烬灰链霉菌培养
属名 Streptomyces
种名加词 cinereogriseus
收藏时间
原始编号 ATCC40125
模式菌株 非模式菌株
主要用途 a:2:{i:0;s:4:分类;i:1;s:4:研究;}
特征特性
具体用途 能抑制阳性细菌、阴性细菌及丝状真菌
生物危害程度 四类
烬灰链霉菌培养实验内容:
1.称量→溶化→调pH→过滤→分装→加塞→包扎→灭菌→无菌检查
2.干热灭菌:装入待灭菌物品→升温→恒温→降温→开箱取物
3.高压蒸汽灭菌:加水→装物品→加盖→加热→排冷空气→加压→恒压→降压回零→排汽→取物→无菌检查
4.过滤除菌:组装灭菌→连接→压滤→无菌检查→清洗灭菌
 烬灰链霉菌培养
烬灰链霉菌培养【标准操作流程】
菌株复苏:(按三区划线法将留菌管内的原始菌株进行复苏)
1) 所有菌株,显色培养基分4区,每区一株,标明菌株号、菌种名常用缩写如下:
cal: 白念珠菌 cgl:光滑念珠菌 cpa: 近平滑念珠菌 ctr: 热带念珠菌 ckr: 克柔念珠菌 cne: 隐球菌,其他菌种标记全名
2) 隐球菌除传显色培养基以外,另传1/2块血平皿上述菌株统一37oC孵育48h
烬灰链霉菌培养菌株操作:
1、安瓿瓶开封:用浸过75%酒精的脱脂棉擦净安瓿管,用火焰加热其顶端,滴少量无菌水至加热顶端使之破裂,用锉刀或者镊子敲下已破裂的安瓿管顶端。
2、菌株恢复培养:用无菌吸管吸取0.3--0.5ml适宜的液体培养基,滴入安瓿管内,轻轻振荡,使冻干菌体溶解呈悬浮状。吸取全部菌体悬浮液,移植于1-2支建议的培养基试管中,并在建议的条件下培养。
3、注意事项:菌种活化前,请将安瓿管保存在6-10℃的环境下,某些菌种经过冷冻干燥保存后,延迟期较长,需要连续两次继代培养才能正常生长
4、复苏后的菌种在传1-2代后使用。
5、暂不启开的安瓿及复苏后需保藏的斜面应于4℃中保藏。
ABCF1 ATP结合盒蛋白家族GCN20F家族1抗体 0.1ml
ABCG1 三磷酸腺苷结合盒亚家族G1抗体 0.1ml
ABCG2/CD338 三磷酸腺苷结合转运蛋白G超家族成员2抗体 0.1ml
KAT4 细胞周期基因1蛋白抗体 0.1ml
ABCG4 ABC膜转运蛋白抗体 0.1ml
ABCG5 三磷酸腺苷结合转运蛋白G超家族成员5抗体 0.2ml
ABCG8 三磷酸腺苷结合转运蛋白G超家族成员8抗体 0.2ml
c-Abl/Abl1 非受体酪氨酸激酶c-Abl抗体 0.1ml
phospho-c-Abl(Tyr134) 磷酸化非受体酪氨酸激酶c-Abl抗体 0.1ml
phospho-c-Abl(Tyr412) 磷酸化非受体酪氨酸激酶c-Abl抗体 0.1ml
phospho-c-Abl(Tyr245) 磷酸化非受体酪氨酸激酶c-Abl抗体 0.1ml
phospho-c-Abl(Tyr204) 磷酸化非受体酪氨酸激酶c-Abl抗体 0.1ml
phospho-c-Abl(Ser735) 磷酸化非受体酪氨酸激酶c-Abl抗体 0.1ml
phospho-c-Abl(Tyr89) 磷酸化非受体酪氨酸激酶c-Abl抗体 0.1ml
phospho-c-Abl(Tyr251) 磷酸化非受体酪氨酸激酶c-Abl抗体 0.1ml
phospho-c-Abl(Tyr272) 磷酸化非受体酪氨酸激酶c-Abl抗体 0.1ml
phospho-c-Abl(Tyr276) 磷酸化非受体酪氨酸激酶c-Abl抗体 0.1ml
SPTLC1 丝氨酸棕榈酰转移酶1抗体 0.2ml
SLC27A5 脂肪酸转运蛋白5抗体 0.2ml
Clathrin heavy chain/Clathrin HC 网格蛋白重链抗体 0.2ml
RAB-14 RAS相关蛋白癌基因Rab14抗体 0.2ml
ARHG7 p21活化蛋白激酶ARHG7抗体 0.2ml
大鼠红细胞生成素受体(EPOR)ELISA Kit,48T/96T
人红细胞生成素(EPO)ELISA Kit,48T/96T
小鼠红细胞生成素(EPO)ELISA Kit,48T/96T
大鼠红细胞生成素(EPO)ELISA Kit,48T/96T
人E选择素(E-Selectin/CD62E)ELISA Kit,48T/96T
小鼠E选择素(E-Selectin/CD62E)ELISA Kit,48T/96T
猴E选择素(E-Selectin/CD62E)ELISA Kit,48T/96T
大鼠E选择素(E-Selectin/CD62E)ELISA Kit,48T/96T
兔子E选择素(E-Selectin/CD62E)ELISA Kit,48T/96T
人凋亡相关因子(FAS/CD95)ELISA Kit,48T/96T
小鼠凋亡相关因子(FAS/CD95)ELISA Kit,48T/96T
猪凋亡相关因子(FAS/CD95)ELISA Kit,48T/96T
大鼠凋亡相关因子(FAS/CD95)ELISA Kit,48T/96T
人凋亡相关因子配体(FASL)ELISA Kit,48T/96T
小鼠凋亡相关因子配体(FASL)ELISA Kit,48T/96T
大鼠凋亡相关因子配体(FASL) ELISA Kit,48T/96T
人酸性成纤维细胞生长因子1(aFGF-1)ELISA Kit,48T/96T
小鼠酸性成纤维细胞生长因子1(aFGF-1)ELISA Kit,48T/96T
大鼠酸性成纤维细胞生长因子1(aFGF-1)ELISA Kit,48T/96T
犬α干扰素(IFN-α)ELISA Kit,48T/96T
鸡α干扰素(IFN-α)ELISA Kit,48T/96T
猫α干扰素(IFN-α)ELISA Kit,48T/96T
人α干扰素(IFN-α)ELISA Kit,48T/96T
小鼠α干扰素(IFN-α)ELISA Kit,48T/96T
猴α干扰素(IFN-α)ELISA Kit,48T/96T
猪α干扰素(IFN-α)ELISA Kit,48T/96T
烬灰链霉菌培养大鼠α干扰素(IFN-α)ELISA Kit,48T/96T
兔子α干扰素(IFN-α)ELISA Kit,48T/96T
人碱性成纤维细胞生长因子4(bFGF-4)ELISA Kit,48T/96T
小鼠碱性成纤维细胞生长因子4(bFGF-4)ELISA Kit,48T/96T
大鼠碱性成纤维细胞生长因子4(bFGF-4)ELISA Kit,48T/96T
人碱性成纤维细胞生长因子6(bFGF-6)ELISA Kit,48T/96T
小鼠碱性成纤维细胞生长因子6(bFGF-6)ELISA Kit,48T/96T
烬灰链霉菌培养保藏方法:
1. 传代培养保藏法
又有斜面培养、穿刺培养、疱肉培养基培养等(后者作保藏厌氧细菌用),培养后于4-6℃冰箱内保存。
2. 液体石蜡覆盖保藏法
是传代培养的变相方法,能够适当延长保藏时间,它是在斜面培养物和穿刺培养物上面覆盖灭菌的液体石蜡,一方面可防止因培养基水分蒸发而引起菌种死亡,另一方面可阻止氧气进入,以减弱代谢作用。
3. 载体保藏法
是将微生物吸附在适当的载体,如土壤、沙子、硅胶、滤纸上,而后进行干燥的保藏法,例如沙土保藏法和滤纸保藏法应用相当广泛。
4. 寄主保藏法
用于目前尚不能在人工培养基上生长的微生物,如病毒、立克次氏体、螺旋体等,它们必须在生活的动物、昆虫、鸡胚内感染并传代,此法相当于一般微生物的传代培养保藏法。病毒等微生物亦可用其他方法如液氮保藏法与冷冻干燥保藏法进行保藏。
5. 冷冻保藏法
可分低温冰箱(-20-30℃,-50-80℃)、干冰酒精快速冻结(约-70℃)和液氮(-196℃)等保藏法。
6. 冷冻干燥保藏法
先使微生物在低温度(-70℃左右)下快速冷冻,然后在减压下利用升华现象除去水分(真空干燥)。有些方法如滤纸保藏法、液氮保藏法和冷冻干燥保藏法等均需使用保护剂来制备细胞悬液,以防止因冷冻或水分不断升华对细胞的损害。保护性溶质可通过氢和离子键对水和细胞所产生的亲和力来稳定细胞成分的构型。保护剂有牛乳、血清、糖类、甘油、二甲亚砜等。
本页产品地址:http://www.geilan.com/sell/show-7904256.html

![]()

 免责声明:以上所展示的[ 烬灰链霉菌培养]信息由会员[上海研生实业有限公司]自行提供,内容的真实性、准确性和合法性由发布会员负责。
免责声明:以上所展示的[ 烬灰链霉菌培养]信息由会员[上海研生实业有限公司]自行提供,内容的真实性、准确性和合法性由发布会员负责。